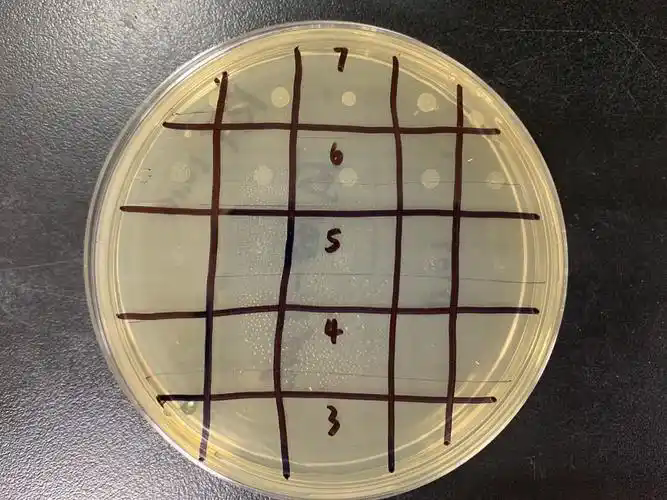

在化妆品行业高速发展的当下,产品质量安全是企业生存的核心命脉,化妆品检验员作为把控质量关的关键岗位,持证上岗已成为行业标配。本文将为你详细解析佛山化妆品检验员证书的报考对象、报考流程、考试内容,并结合兰冠教育学院的专属课程,助你高效拿证、顺利上岗。
一、佛山化妆品检验员培训报考对象:明确适配人群佛山化妆品检验员证书报考面向三类核心人群,门槛清晰、覆盖广泛:
1.行业从业者:化妆品生产企业、代工厂、质检部门的化验员、质检员、品控专员;品牌方质量管理人员、实验室技术人员,需持证规范履职。
2.转岗求职人群:希望切入化妆品行业的化学分析、质检相关专业毕业生,或有实验室操作基础、想转型检验岗位的职场人。
3.技能提升人群:对化妆品检测技术感兴趣,计划从事第三方检测机构、药监部门辅助岗位的技术爱好者,需满足基础学历或实操能力要求。
二、佛山化妆品检验员培训报考流程:四步高效拿证
佛山化妆品检验员证书报考流程清晰透明,全程可线上线下结合:
1.选择正规机构报名
优先选择具备深耕行业的机构,如兰冠教育学院。提交报名材料:身份证正反面、学历证明、工作证明(模板由机构提供)、1寸蓝底证件照,填写《化妆品检验员认定申请表》,机构审核通过后发放备考资料。
2.参加系统培训(核心环节)
报名成功后,参加兰冠教育学院定制课程培训,涵盖理论精讲、实操演示、案例分析、真题演练,总课时约80-120小时,分线上直播+线下面授两种模式,适配不同人群时间需求,确保零基础也能吃透考点。
3.参加统一考试
考试由兰冠教育学院组织,每月一期,分为两部分:
理论考试(机考):满分100分,60分合格,题型为单选、多选、判断,考核化妆品检验基础、法规标准、质量控制等内容。
实操考试:满分100分,70分合格,现场操作化妆品微生物、理化指标检测,如pH值、重金属、菌落总数、霉菌酵母菌等,考察实操规范与结果准确性。
考试内容紧扣化妆品检验岗位核心技能,分为理论与实操两大模块,兰冠教育学院课程完全覆盖考点,针对性极强:
1.理论知识(占比40%)
基础学科:化学基础(溶液配制、酸碱滴定、氧化还原反应)、仪器分析原理(高效液相色谱、原子吸收光谱、紫外可见分光光度计)。
行业法规:《化妆品监督管理条例》《化妆品安全技术规范(2015年版)》《化妆品标签管理规定》,重点考核原料检验、成品检测、留样管理要求。
质量控制:检验方法验证、误差分析、实验室安全规范、留样管理、不合格品处理流程。
2.实操技能(占比60%)
理化检测实操:化妆品pH值测定(电位法)、重金属(铅、砷、汞)检测(原子吸收法)、甲醇含量测定、粘度测定(旋转粘度计)。
微生物检测实操:无菌操作规范、培养基制备、菌落总数检测(平板计数法)、霉菌酵母菌检测(涂布法)、金黄色葡萄球菌、大肠杆菌检测。
仪器操作实操:高效液相色谱仪(HPLC)操作(流动相配制、色谱柱维护、结果分析)、紫外分光光度计使用、pH计校准与操作。
四、佛山化妆品检验员岗位职责:明确岗位核心工作
持证上岗后,佛山化妆品检验员主要在生产企业质检部、第三方检测机构、品牌方质量部任职,核心职责围绕“质量把控、合规检测、技术支持”展开:
1.原料检验:对化妆品原料(如防腐剂、香精、活性成分)进行理化指标、重金属、微生物检测,判定原料是否符合《化妆品安全技术规范》,杜绝不合格原料流入生产。
2.成品检测:化妆品出厂前,全面检测成品pH值、重金属、微生物(菌落总数、霉菌酵母菌、致病菌)、有效成分含量、稳定性(耐热、耐寒、离心试验),确保成品安全合规。
3.过程控制:跟踪生产环节关键控制点(如乳化、灌装、灭菌),定期抽样检测,及时发现质量隐患,避免批次不合格。
4.报告与留样:出具规范的检验报告,记录检验数据;按要求留存样品,建立留样台账,配合药监部门飞行检查、日常抽检。
5.法规与技术更新:持续学习最新化妆品法规、检测标准,参与企业检验方法优化、仪器设备维护,为产品研发提供技术支持,如新配方稳定性检测。
化妆品检验员证书是进入行业、提升职业竞争力的“敲门砖”,佛山作为化妆品产业聚集地,持证检验员缺口持续扩大。兰冠教育学院凭借专业课程、优质师资、一站式服务,已帮助数千名学员顺利拿证、就业。
